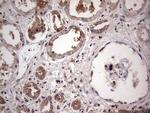
PKM2 Antibody in Immunohistochemistry (Paraffin) (IHC (P))

Search
OriGene
PKM2 Monoclonal Antibody (OTI11B11), TrueMAB™
{{$productOrderCtrl.translations['antibody.pdp.commerceCard.promotion.promotions']}}
{{$productOrderCtrl.translations['antibody.pdp.commerceCard.promotion.viewpromo']}}
{{$productOrderCtrl.translations['antibody.pdp.commerceCard.promotion.promocode']}}: {{promo.promoCode}} {{promo.promoTitle}} {{promo.promoDescription}}. {{$productOrderCtrl.translations['antibody.pdp.commerceCard.promotion.learnmore']}}
产品信息
TA190264
种属反应
宿主/亚型
分类
类型
克隆号
抗原
偶联物
形式
浓度
纯化类型
保存液
内含物
保存条件
运输条件
产品详细信息
Synthetic peptide sequence is LRRLAPITSDPTEATAVGAV
靶标信息
PKM2 is a pyruvate kinase that catalyzes the production of phosphoenolpyruvate from pyruvate and ATP. PKM2 has been shown to interact with thyroid hormone, and thus may mediate cellular metabolic effects induced by thyroid hormones. PKM2 has been found to bind Opa protein, a bacterial outer membrane protein involved in gonococcal adherence to and invasion of human cells, suggesting a role of this protein in bacterial pathogenesis. Three alternatively spliced transcript variants encoding two distinct isoforms of PKM2 have been reported.
仅用于科研。不用于诊断过程。未经明确授权不得转售。
篇参考文献 (0)
生物信息学
蛋白别名: CTHBP; Cytosolic thyroid hormone-binding protein; epididymis secretory protein Li 30; isozymes M1/M2; m2pk; OIP-3; OPA-interacting protein 3; p58; PK, muscle type; Pyruvate kinase 2/3; pyruvate kinase isozymes M1/M2; Pyruvate kinase muscle isozyme; Pyruvate kinase PKM; THBP1; Threonine-protein kinase PKM2; Thyroid hormone-binding protein 1; thyroid hormone-binding protein, cytosolic; tu; Tumor M2-PK; Tyrosine-protein kinase PKM2
基因别名: CTHBP; HEL-S-30; OIP3; PK2; PK3; PKM; PKM2; TCB; THBP1
UniProt ID: (Human) P14618
Entrez Gene ID: (Human) 5315